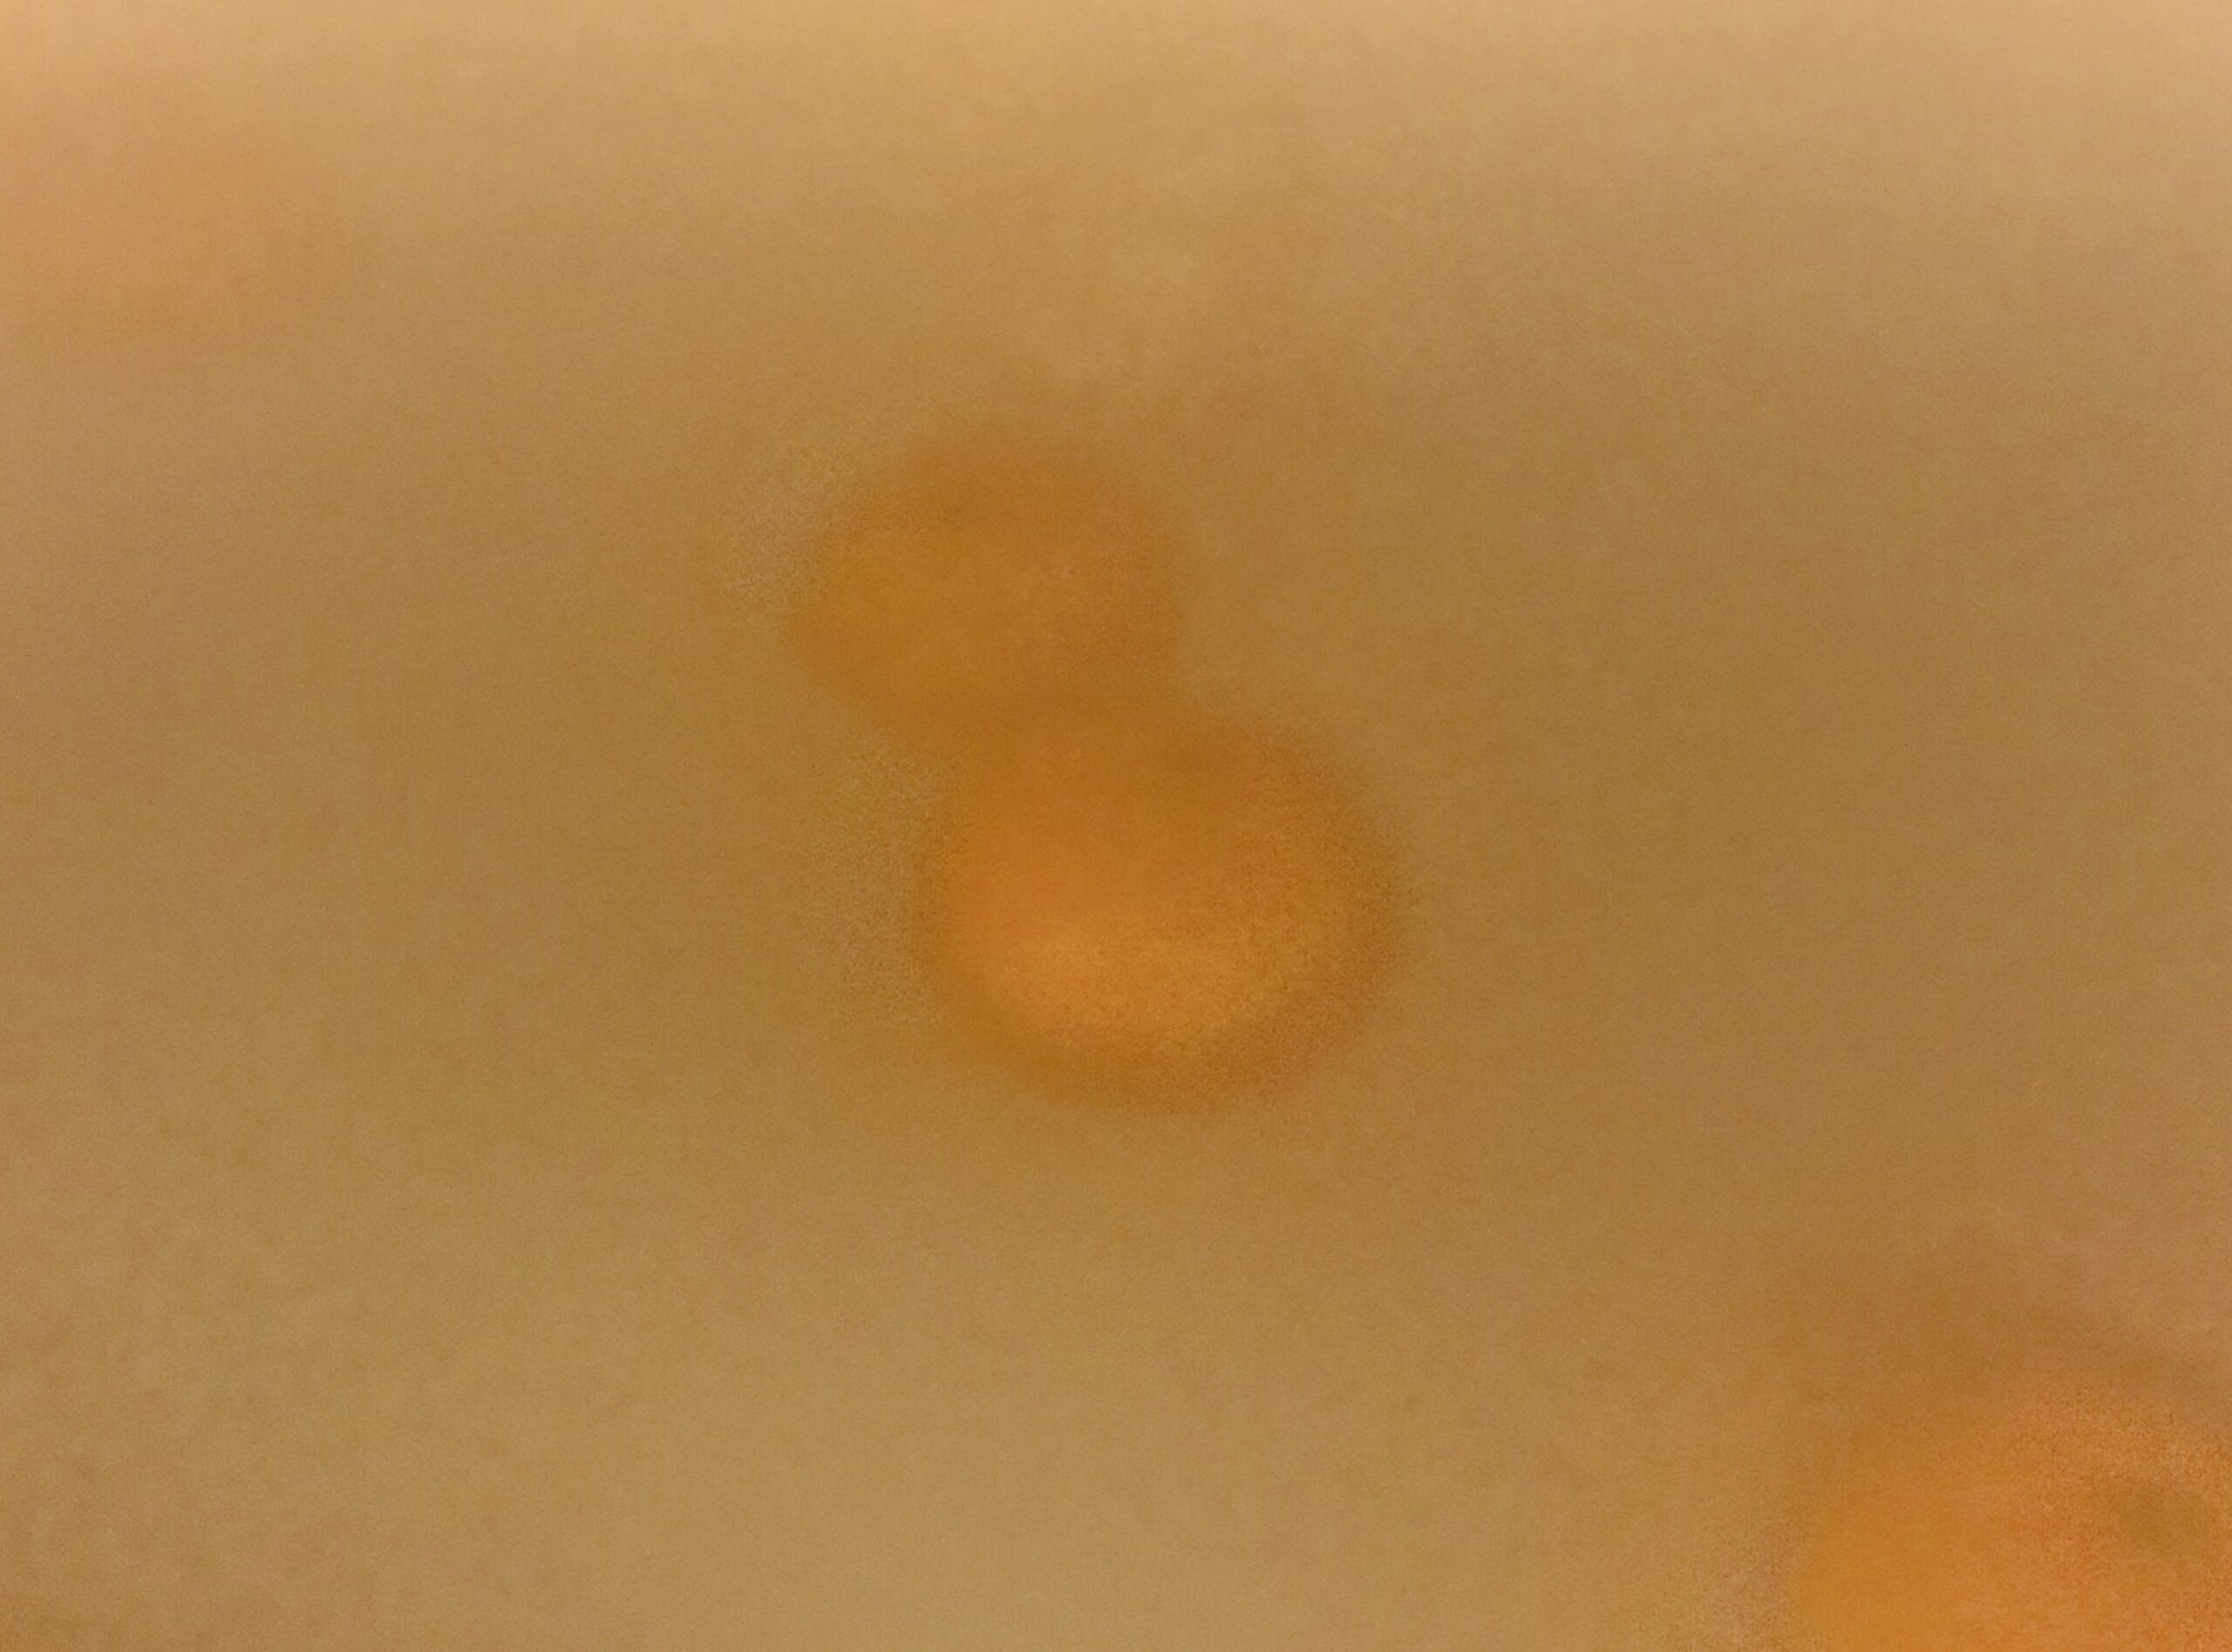

12月の凍れる夜ふけ。湯けむる湯船に酒飲みなら徳利とおちょこを持ち込むに違いない。私は酒飲みではないので、ミカンを湯に放り込んだ。洗い桶で農薬を洗い流してからだけど。冬ならではの一興だ。子どものころからやっている。
これは母の真似だった。20代か30代か、そのころの若かりし母はなかなか風呂場から出てこなかった。湯船に浮かべたミカンを食べながら、『花とゆめ』『マーガレット』『ジャンプ』などなどのマンガを読んでいたのである。
のんびりして、なかなか良いことだと思った。これにならい、子どもの時分から、湯船にミカンを浮かべて本を読むようになった。湯気で紙はヘタってしまうのが難点けれど。言うまでもなく私も長風呂だった。
ミカンを湯船に浮かべるとアロマ気分だ。他にも、食べられないレモンの端っこなどを網に入れて、湯船に浮かべる。大変に気持ちが良い。ミカンは真夜中に浮かぶ木星のようだ。周回するミカンをつかみ、皮をむくと夢見る香りが広がる。一粒口の中に放り込み、またスマホ読書だ。
母とは一緒に風呂に入る年齢ではないので、今はどうしているか分からないけれど、私はスマホで読書している。無印良品で見つけたスマホ用防水ケースと出合ってだいぶ生活が変わった。
今宵もミカンを浮かべた湯船からブログの更新をしている。無数の木星たちが回っている。